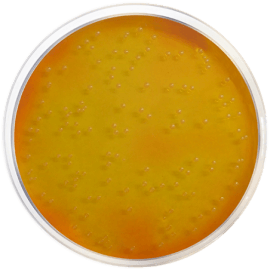
main product photo

Close
MANNITOL SALT AGAR (M.S.A.) (Eur. Pharma.) 500 grams/bottle
SKU
CDL/1062
Brand
CONDALAB
Pre-order (Deliver in 8 to 12 weeks)
Mannitol Salt Agar (MSA) (Chapman Medium) is a selective medium prepared according to the recommendations of Chapman for the isolation of presumptive pathogenic staphylococci. Most of the other bacteria are inhibited by the high concentration of Sodium chloride.
The pancreatic digest of casein, peptic digest of animal tissue and beef extract provide nitrogen, vitamins, minerals and amino acids essential for growth. Mannitol is the carbohydrate energy source and phenol red is the pH indicator. Sodium chloride supplies essential electrolytes for transport and osmotic balance. Bacteriological agar is the solidifying agent.
The degradation of mannitol by bacteria produces acidic products that change the color of the medium from pink to yellow. Due to its high content of sodium chloride, a heavy inoculum of the material under study can be used.
The European Pharmacopoeia, USP recommends this media in the paragraph 2.6.13: "Microbiological examination of non-sterile products: Test for specified microorganisms" for the testing of Staphylococcus aureus in products.
The addition of 5% Egg Yolk Emulsion (Cat. 5152) allows detecting the lipase activity of staphylococci, as well as mannitol fermentation. The high concentration of salt in the medium clears the egg yolk emulsion, and lipase production is detected as a yellow opaque zone around the colonies of staphylococci producing this enzyme. This phenomenon, together with a positive coagulase test, confirms the organism as a pathogenic Staphylococcus.
Mannitol Salt Agar (MSA) (Chapman Medium) is a selective medium prepared according to the recommendations of Chapman for the isolation of presumptive pathogenic staphylococci. Most of the other bacteria are inhibited by the high concentration of Sodium chloride.
The pancreatic digest of casein, peptic digest of animal tissue and beef extract provide nitrogen, vitamins, minerals and amino acids essential for growth. Mannitol is the carbohydrate energy source and phenol red is the pH indicator. Sodium chloride supplies essential electrolytes for transport and osmotic balance. Bacteriological agar is the solidifying agent.
The degradation of mannitol by bacteria produces acidic products that change the color of the medium from pink to yellow. Due to its high content of sodium chloride, a heavy inoculum of the material under study can be used.
The European Pharmacopoeia, USP recommends this media in the paragraph 2.6.13: "Microbiological examination of non-sterile products: Test for specified microorganisms" for the testing of Staphylococcus aureus in products.
The addition of 5% Egg Yolk Emulsion (Cat. 5152) allows detecting the lipase activity of staphylococci, as well as mannitol fermentation. The high concentration of salt in the medium clears the egg yolk emulsion, and lipase production is detected as a yellow opaque zone around the colonies of staphylococci producing this enzyme. This phenomenon, together with a positive coagulase test, confirms the organism as a pathogenic Staphylococcus.
| Brand | CONDALAB |
|---|
Write Your Own Review

Validate your login